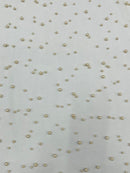
Heavy Scattered Pearls Studded Mesh Fabric| New Creations Fabric & Foam Inc. - New Creations Fabric & Foam Inc

NO RETURNS on any cut fabric (anything that is cut from the manufacturer's roll which is 40 yards or more), only damaged or incorrect items will be accepted for return.
Image colors will vary per screen. We do not accept returns on color differentiation. For precise color matching, we recommend purchasing our Color Cards or Swatches.
To be eligible for a return, your item(s) must be unused and in the same condition that you received it. It must also be in the original packaging.
Our policy is active for 15 days. If 15 days have gone by since your purchase, unfortunately, we cannot offer you a refund or exchange.
To complete your return, we require a receipt or proof of purchase.
Please do not send your purchase back to the manufacturer.
REFUNDS (if applicable)
Once your return is received and inspected, we will send you an email to notify you that we have received your returned item. We will also notify you of the approval or rejection of your refund.
If you are approved, then your refund will be processed, and a credit will automatically be applied to your credit card or original method of payment, within a certain amount of days.
LOST / STOLEN PACKAGES
If your order says "DELIVERED", but you did not receive your package, please notify us after 24 hours and within 7 days and contact your local post office to see if your shipment is being held. Most of the time, the carrier has marked your item as delivered a little too early, in most cases it ends up being delivered within 24 hours. If you consider your package lost or stolen, please email us right away. We can provide you with all the information we have to help you locate your package, including; tacking number, ship date, and last known location.
New Creations Fabric & Foam Inc will NOT contact any parcel service on your behalf. When the package leaves our facility the customer assumes all responsibility for the package.
New Creations Fabric & Foam Inc is NOT responsible for the refund or reship of any packages due to the following circumstances:
- Held or returned shipments due to incorrect address or undeliverable.
- Shipments lost at any point in the parcel process.
- Shipments stolen at any point in the parcel process.
If you are concerned with receiving your order to your address due to lost or stolen shipments in the past, we do ship to PO boxes or we recommend that you ship your order to a secure mailbox.